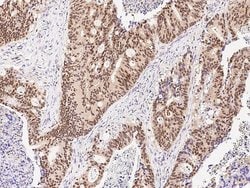
Invitrogen ARL4A Polyclonal Antibody 100 &mu;L; Unconjugated:Antibodies,

missing translation for 'onlineSavingsMsg'
Learn More
Learn More
Invitrogen™ ARL4A Polyclonal Antibody


Rabbit Polyclonal Antibody
Brand: Invitrogen™ PA581144
This item is not returnable.
View return policy
Description
This product is preservative free. It is recommended to add sodium azide to avoid contamination (final concentration 0.05%-0.1%). This antibody has specificity for Human ARL4A/ARL4.
ARL4A (ADP-ribosylation factor-like 4A) is a member of the ADP-ribosylation factor family of GTP-binding proteins. ARL4A is similar to ARL4C and ARL4D and each has a nuclear localization signal and an unusually high guaninine nucleotide exchange rate. ARL4A is located in both the nuclear and extranuclear cell compartments. Multiple transcript variants encoding the same protein have been found for this gene.
Specifications
| ARL4A | |
| Polyclonal | |
| Unconjugated | |
| ARL4A | |
| ADP ribosylation factor like GTPase 4A; ADP-ribosylation factor like GTPase 4A; ADP-ribosylation factor-like 4; ADP-ribosylation factor-like 4A; ADP-ribosylation factor-like protein 4A; ADP-ribosylation-like 4; AI467555; Arl4; ARL4A; OTTHUMP00000155200; OTTHUMP00000201575 | |
| Rabbit | |
| Antigen affinity chromatography, Protein A | |
| RUO | |
| 10124 | |
| Store at 4°C short term. For long term storage, store at -20°C, avoiding freeze/thaw cycles. | |
| Liquid |
| Immunohistochemistry (Paraffin) | |
| 1 mg/mL | |
| PBS with no preservative | |
| P40617 | |
| ARL4A | |
| A synthetic peptide corresponding to the center region of the Human ARL4A/ARL4. | |
| 100 μL | |
| Primary | |
| Human | |
| Antibody | |
| IgG |
Product Content Correction
Your input is important to us. Please complete this form to provide feedback related to the content on this product.
Product Title
Spot an opportunity for improvement?Share a Content Correction